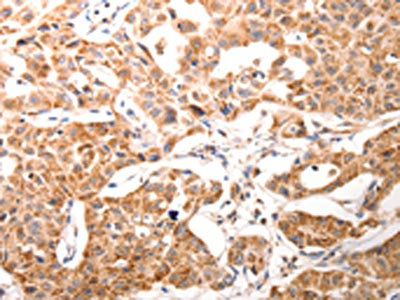
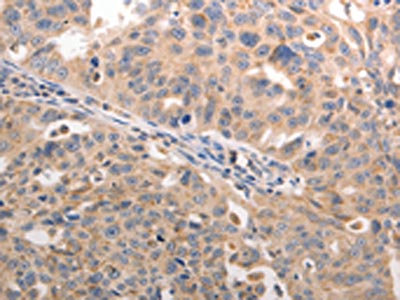

-
中文名稱:BGLAP兔多克隆抗體
-
貨號:CSB-PA277795
-
規格:¥1100
-
圖片:
-
The image on the left is immunohistochemistry of paraffin-embedded Human ovarian cancer tissue using CSB-PA277795(BGLAP Antibody) at dilution 1/60, on the right is treated with synthetic peptide. (Original magnification: ×200)
-
The image on the left is immunohistochemistry of paraffin-embedded Human lung cancer tissue using CSB-PA277795(BGLAP Antibody) at dilution 1/60, on the right is treated with synthetic peptide. (Original magnification: ×200)
-
-
其他:
產品詳情
-
Uniprot No.:
-
基因名:
-
別名:BGLAP antibody; BGP antibody; Bone gamma carboxyglutamate (gla) protein antibody; Bone gamma carboxyglutamate gla protein osteocalcin antibody; Bone gamma carboxyglutamate protein antibody; Bone Gla protein antibody; Gamma carboxyglutamic acid containing protein antibody; Gamma-carboxyglutamic acid-containing protein antibody; OC antibody; OCN antibody; OSTCN_HUMAN antibody; Osteocalcin antibody; OTTHUMP00000016586 antibody; PMF1 antibody
-
宿主:Rabbit
-
反應種屬:Human
-
免疫原:Synthetic peptide of Human BGLAP
-
免疫原種屬:Homo sapiens (Human)
-
標記方式:Non-conjugated
-
抗體亞型:IgG
-
純化方式:Antigen affinity purification
-
濃度:It differs from different batches. Please contact us to confirm it.
-
保存緩沖液:-20°C, pH7.4 PBS, 0.05% NaN3, 40% Glycerol
-
產品提供形式:Liquid
-
應用范圍:ELISA,IHC
-
推薦稀釋比:
Application Recommended Dilution ELISA 1:1000-1:5000 IHC 1:50-1:200 -
Protocols:
-
儲存條件:Upon receipt, store at -20°C or -80°C. Avoid repeated freeze.
-
貨期:Basically, we can dispatch the products out in 1-3 working days after receiving your orders. Delivery time maybe differs from different purchasing way or location, please kindly consult your local distributors for specific delivery time.
-
用途:For Research Use Only. Not for use in diagnostic or therapeutic procedures.
相關產品
靶點詳情
-
功能:Constitutes 1-2% of the total bone protein. It binds strongly to apatite and calcium.
-
基因功能參考文獻:
- The results of this study suggest that serum osteocalcin is associated with the onset of puberty in girls. PMID: 30089739
- The correlation between Mycobacterium avium subsp. paratuberculosis (MAP) infection and elevation of sera ucOC, reduction of active osteocalcin and increased calcium supports MAP infection role in Crohn's disease and complications with osteoporosis. PMID: 29638140
- The results showed no significant correlation between osteocalcin HindIII gene polymorphism and bone mineral density (BMD) and therefore osteocalcin HindIII gene polymorphism may not have major effects on BMD variation in postmenopausal North Indian women. PMID: 30179426
- Decreased circulating carboxylated osteocalcin is associated with low-energy bone fractures in children. PMID: 29882816
- a decrease in serum osteocalcin levels is associated with future development of type 2 diabetes mellitus. PMID: 28766135
- Findings from the available data indicated an overall significant inverse association between serum osteocalcin and body mass index--{REVIEW} PMID: 28822067
- relatively lower serum osteocalcin levels were associated with a higher risk of MACE in Chinese men with CAD PMID: 28921598
- undercarboxylated form of osteocalcin in serum not related significantly to semen parameters or measured hormones in male infertility PMID: 28000970
- serum level not correlated with gender, race/ethnicity, age, diabetes type, BMI percentile, random C-peptide, glucose, or HbA1c at pediatric diabetes diagnosis; serum level inversely correlated with HbA1c at first office visit following diagnosis PMID: 28093839
- Serum osteocalcin was directly and independently correlated with circulating uric acid in a population of healthy obese subjects. PMID: 28847266
- gamma-carboxylation of OCN on Glu17 residue correlates with insulin resistance and subclinical inflammation, suggesting that gamma-carboxylation of OCN negatively regulates its endocrine action PMID: 28242268
- There were differences in the associations between total osteocalcin and glucose metabolism in Han and Uygur T2DM patients, indicating genetic factors may play a role in modulating OC and glucose metabolism in different ethnic population. PMID: 28732499
- The study demonstrated that undercarboxylated osteocalcin (ucOC) is related to 25(OH)D and adiponectin concentrations. Both ucOC and 25(OH)D were lower in overweight and obese adolescents. PMID: 28443718
- Increased advanced glycation end products and protein oxidative damage markers in the course of obesity may contribute to decreased carboxylated osteocalcin serum level. PMID: 28841723
- Progressive calcification of atherosclerotic plaques is accompanied by insignificant accumulation of calcitonin and osteoprotegerin, whereas the osteocalcin expression significantly increased during calcification. PMID: 28429221
- Undercarboxylated osteocalcin reflects the reserve capacity of beta-cell function, such as the bolus insulin secretion ability in patients with type 2 diabetes. PMID: 27889949
- XPS showed that similar amounts of hOC and dhOC were absorbed onto hydroxyapaptite and octacalcium phosphate surfaces, but ToF-SIMS detected some small differences in the amino acid fragment intensities on these surfaces for adsorbed hOC and dhOC. PMID: 28521505
- Common polymorphism rs1800247 in osteocalcin gene was associated with hypertension and diastolic blood pressure levels. The association of rs1800247 with hypertension was affected by its interaction with HOMA-IR. PMID: 27251081
- These findings indicate the undercarboxylated form of OC is not implicated in age-related changes in skeletal muscle or adipose tissue mass in older community-dwelling adults. PMID: 27604070
- Demonstrate a positive association between osteocalcin, a factor known to regulate bone remodelling, with cognitive performance in older non-demented women. PMID: 27515675
- Common genetic variants of the osteocalcin gene may not be a major contributor to variations in serum osteocalcin or BMD in postmenopausal and elderly Chinese women. PMID: 28002816
- Several detected relations between OCN and metabolites were strongly linked to renal function, however, a number of associations remained significant after adjustment for renal function. Intermediates of proline catabolism were associated with OCN reflecting the implication in bone metabolism. PMID: 28922389
- Low serum osteocalcin concentrations are associated with type 2 diabetes. PMID: 27061949
- Decreased blood concentration of Carboxylated osteocalcin is associated with metabolic complications and inflammation. PMID: 27667744
- Total and undercarboxylated osteocalcin levels were significantly correlated with insulin secretion and insulin resistance indices, but not adiponectin levels, in pregnant women. PMID: 26708046
- Osteocalcin and Sex Hormone Binding Globulin Compete on a Specific Binding Site of GPRC6A. PMID: 27673554
- Osteocalcin plays an essential role for the maturation of mineral species and modulates osteogenic differentiation of mesenchymal stromal cells (MSCs). PMID: 28106724
- Serum osteocalcin levels in pediatric obstructive sleep apnea hypopnea syndrome patients were significantly lower than normal controls before adenotonsillectomy. PMID: 26938749
- the relationship between serum osteocalcin and glucose metabolism parameters in liver transplantation recipients, was examined. PMID: 26743527
- Reduced plasma Osteocalcin levels are associated with cardiovascular and metabolic diseases. PMID: 26863345
- An overview of osteocalcin progress. PMID: 26747614
- the BMP-2/Smad1/5/RUNX2 signaling pathway participates in the silicon-mediated induction of COL-1 and osteocalcin synth PMID: 27025722
- Data indicate that lower osteocalcin was an independent predictor of worse cognitive performance on multivariate analysis. PMID: 26406918
- A common polymorphism rs1800247 in osteocalcin gene may effect the risk of osteoporosis and fracture and serum osteocalcin levels in Chinese. PMID: 26194493
- There is an inverse relationship between the visfatin and undercarboxylated osteocalcin in type 2 diabetes patients with diabetic kidney disease. PMID: 26922969
- This study investigated osteocalcin, metabolic parameters and anthropometric characteristics in normal weight and overweight/obese children. PMID: 26772621
- Nonalcoholic fatty liver disease negatively associated with right-hip bone mineral density and serum osteocalcin in Korean men. PMID: 26636404
- The aims of this study were to evaluate OCN and sclerostin levels in subjects who underwent coronary artery bypass graft (CABG) surgery compared with those in normal controls. PMID: 26576474
- serum level not associated with weight loss or body fat percentage PMID: 25963022
- Serum osteocalcin levels are inversely correlated with nonalcoholic fatty liver disease in postmenopausal Chinese women with normal blood glucose levels. PMID: 26567728
- Serum total osteocalcin level is significantly lower in 2 diabetes mellitus patients than controls. PMID: 26372899
- Elevated serum preptin and decreased osteocalcin concentrations, together with insulin resistance, are associated with obesity and overweight. PMID: 25675353
- gestational diabetes is not associated with osteocalcin, under-carboxylated osteocalin, osteopontin and leptin and does not correlate with insulin resistance. PMID: 25480426
- Serum uOC levels in non-dialysis patients with CKD are significantly lower than those in healthy individuals, and uOC is closely associated with subclinical atherosclerosis in CKD patients. PMID: 26381729
- Endocrine function of osteocalcin and the cell biology events that allow osteocalcin to become a hormone. [review] PMID: 25577163
- Data indicate that higher osteocalcin (OC) or its undercarboxylated form (ucOC) concentration and ucOC to osteocalcin ratio (OCR) were associated with the risk of coronary calcification in men. PMID: 25868823
- Data suggest that a low serum osteocalcin level was an independent risk factor for abdominal obesity. PMID: 25871789
- Correlation between osteocalcin-positive endothelial progenitor cells and spotty calcification in patients with coronary artery disease PMID: 25644945
- These findings unequivocally document that increased vitamin K intake reduces the uncarboxylated form of OCN PMID: 25855755
- Serum osteocalcin level was not independently associated with C-IMT in a metabolically healthy Chinese population. PMID: 26077201
顯示更多
收起更多
-
亞細胞定位:Secreted.
-
蛋白家族:Osteocalcin/matrix Gla protein family
-
數據庫鏈接:
Most popular with customers
-
YWHAB Recombinant Monoclonal Antibody
Applications: ELISA, WB, IHC, IF, FC
Species Reactivity: Human, Mouse, Rat
-
Phospho-YAP1 (S127) Recombinant Monoclonal Antibody
Applications: ELISA, WB, IHC
Species Reactivity: Human
-
-
-
-
-
-